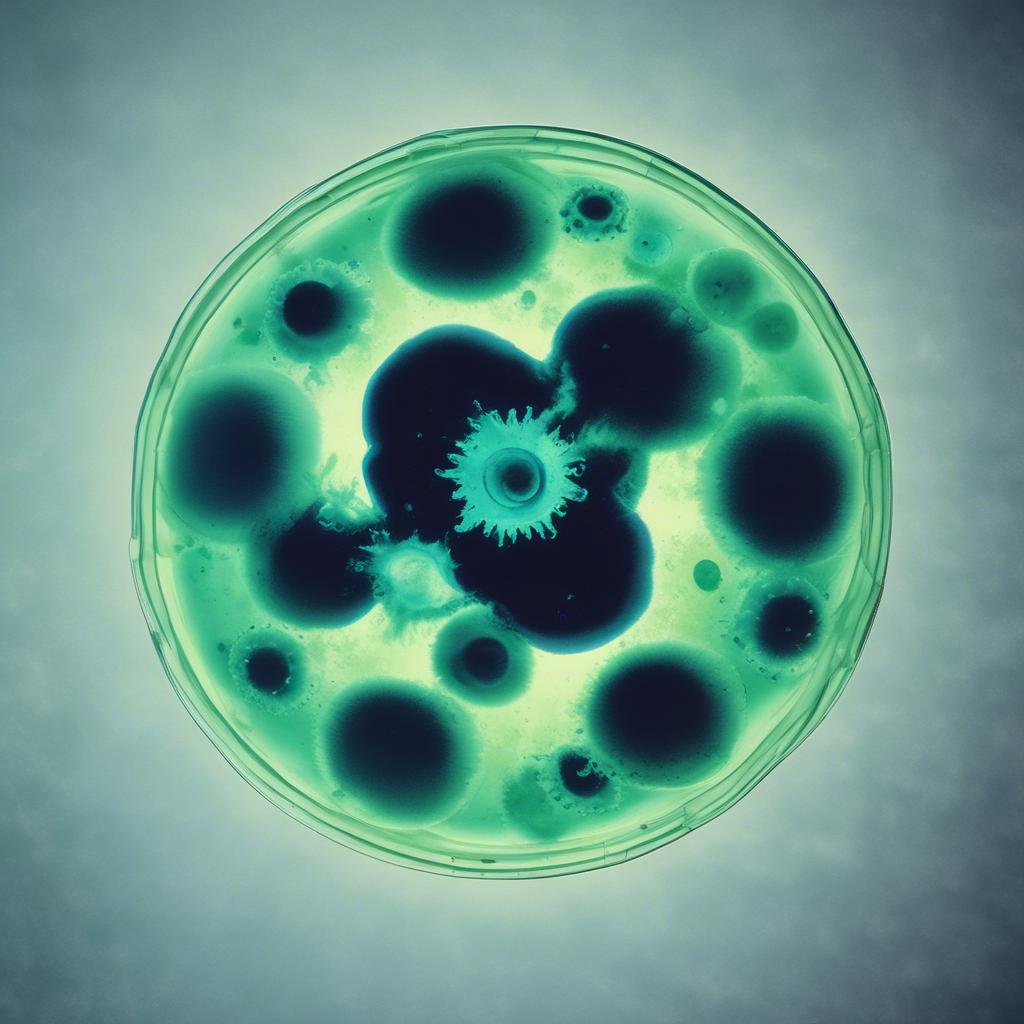
Song Image

3:01

1:50

Slow Burn
v3.5
jumpstyle-glitch, sultry, horny, passionate, sensual, throat-singing, ass-twerking, female cure, haunting
0:45

2:40

It's love
v3.5
ASMR-bass-vocals, intense love, future audiophile instruments, Tuvan throat singing choir
2:31

Boobie Bubble
v3.5
Bubblegum, bubblegum-j-core, intimate clear vocals, sweating, curly, Toha, Cimbalom, lazy choirs, outlandish, overwhelming, cruising cadillac, casino, sugar trees on ashpalt crocodiles, omg! omg!
2:39

Non-logiccore-rap, Non-logicwave-rap, Michigan, Midnight, Sun, South, East, West, collapsing blue screen, electro-cello
2:47

Locked in
v3.5
Random, horrorcore, Paranormal persian-schranz-waltz, organized lasership, Zion, chainsawed choir, blue-screen, cute, amputated heart, lunatic high-pitch-deep-pitch-vocals, crossed out instruments
2:36

2:59

future-audiophile-tropical-schranz, dissonant christmas-bells, detached off-beat phonkaloid avantgarde-vocals, dystopian, laid-back, eerie sweeps, tropical ambient, cyber-ducks flapping circus
5:19

cabaret, opera, deep techno, violin, cello, illbient, bells, bass trap
1:39

rainbow
v3.5
rainbow, double-rainbow, triple-rainbow, quadruple-rainowl, hyper-rainbow, wob'n'air
1:37

Unusual Mellow Rockabilly, Dreamlike Remorse-chant, slow, vulnerability, regret over grumpiness, Apologetic Tone
3:06

3:29

Horror-Dark-Psy-Tekk-Persian-Classic, Oud, Psychedelic, Female-Choir, high-pitch, haunting, otherworldly
3:21

TRUESAND 1
v3.5
Darpsy-Yodel, Audiophile-Wizard-Screamed-Vocals, Tunis, Terrifying, melted face, stairs on automobile trees, one copy left
2:31

rockabilly-gabber, sultry, groovy, raspy vocals, euphoric, babble ambient, city noises
1:29

2:40

Split in egg
v3.5
Splitting an egg in half of the time that it takes to listen to this song, The other half which is not listening rents a skeleton for the purpose of thinking without the ears being puppies in the back
2:34

1:52

4:00

experimental opera, omnigenre, HD audio, unconventional sound structures, avant-garde vocals, nightmarish lolicore vibe, schranz, hurdy gurdy, theremin, non-logic dice-rolling, future ASMR soundscape
3:45

Deep Thunder, field recordings, folk fusion, Ukraine, organic tekk, mbira, dulcimer, rubato ghost, Shift time signature
4:00

1:49

1:14

2:25

see just in time
v3.5
flichty, fkldo ihjo, ighro eighope, irg poiqe, rgopei rgopi erh goipv herpo g, moscow, collar, 498, look, blink-bling
2:43

wild Sultry seductive adventurous Cumbia, deep male voice, primal Moaning-Groaning-throaty-vocals, grunted bass, taboo, haunted, sexy slow hypnotic body fx, slurpy, twerks, cumbia, salsa, hot, hot
3:21

2034, ASMR-werewolf-jazzdrill, countertenor-grindcore-vocals, futuristic audiophile ritual grindcore bass howls
4:00

3:02

3:32

Horror-Dark-Psy-Tekk-Persian-Classic, Oud, Psychedelic, Female-Choir, high-pitch, haunting, otherworldly
4:00

2:15

grim sinister Voodoo-plunderphonics-witchhouse, brain organoids, Tanzania, kingdom, post-immortal-rave, non-mortal
3:59

The Cruel Azure
v3.5
Post-Deaththreat, Paranormal persian-gabber-waltz, brain-eating-lasers, Zion, chains, chainsaws, axes, raspy mariachi-machine-guns, endless torture, memorable blue-screen trumpets, sound amputation
4:00

3:54

1:51

2:58

2:18

darbuka, flamenco urbano, marching band, trombone, tuba, paranormal horror
3:35

32-bit, oldschool ebm-chiptune, atonal, ms-dos, midi, tracker, slow bpm, hypnotic, Germany, eerie, quirky grindcore-vocals, chipcore, circus, distorted, joker, joker, joker, joker, joker
4:00
amoeba funeral
v3.5
oldschool-industrial-chiptune, 32-bit-christmas bells, hypnotic martialoid, Germany, eerie, distorted, joker, hoover, cursed voice, traditional demonic soundscape, funeralwave, amoebaoid
3:09

4:00

Flightless Bird
v3.5
Dangerous suicidal grunge, slow, non-joyful, delirious, non-traditional, future free improvisation, cursed thin male voice, non-quality recording, looser, giving up, depressing soundscape
3:09

Beatbox, Electric-Vocals, Vocal-Percussion, Mouth-Drums, Basslines, Rhythmic-Vocals, Layered-Beats, Dynamic-Grooves
4:00

Dangerous Martial industrial, oldschool-ebm, relentless, drumrolls, surprising, klezmer, oud, trombone, cold vocaloid, patriotic, euphoric, manic, mechanical soundscape, dreamy hoover, cute glitches
2:51

=-=-=_-==_--
v3.5
subtle experimental avant-garde, mini-disc, found footage, clicks'n'cuts, modular synth, audiophile vocals
3:54

Thank, A Tank
v3.5
experimental, 90s, underground hip hop, atonal turntableism, whimsical soundscape, lunatic vocals, powerful, oldschool rap, yo
2:36

Lie
v3.5
epic radio-edit, outsider, sound, sound effects, turntablism, lie, Grandmaster







